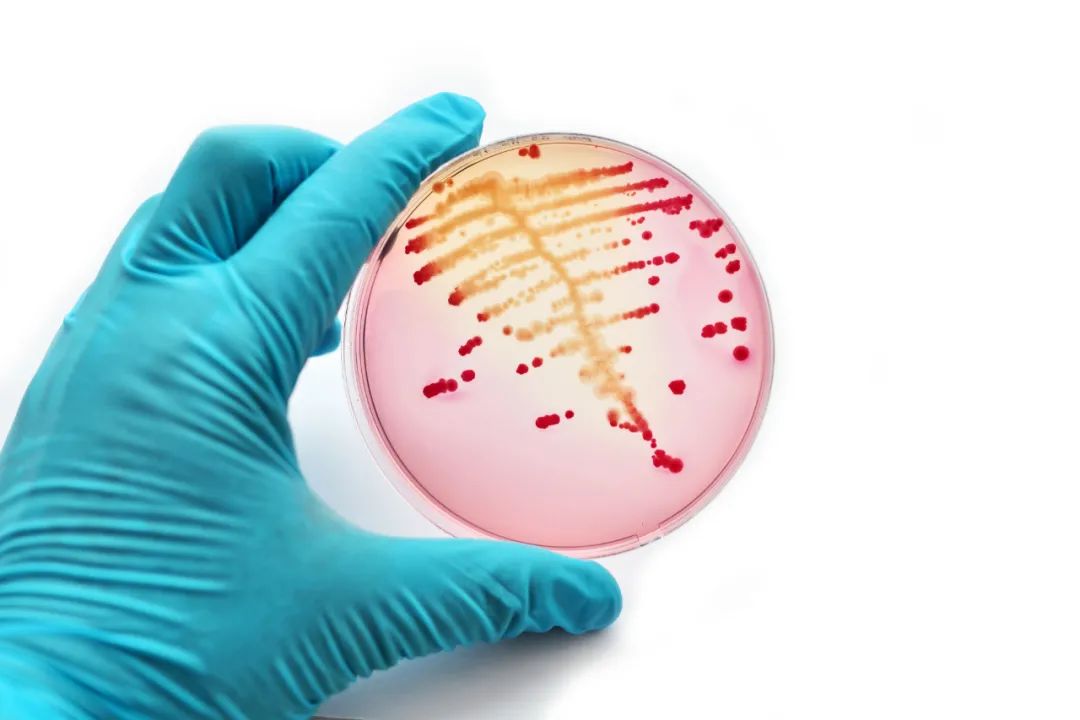
HPV感染会致癌吗？宫颈糜烂要治疗吗？一文解答你的所有疑问

瘙痒、异味、炎症…… 妇科问题五花八门,说到底都和这个地方没有做好保护有一定关系。
这个部位就是——宫颈。作为女性生殖系统中重要的组织器官之一,宫颈几乎承包了女性一生中的妇科、产科、计划生育、妇女保健和生殖健康等疾病防治和保健问题。
今天和广大女性一次聊完有关宫颈的那些事!全面了解 宫颈糜烂、宫颈炎、宫颈癌 ……
为何宫颈是女性健康“最后防线”?
宫颈,虽然日常彼此“见不上面”,但不妨碍它成为女性健康的“守门人”。
从位置上说起,宫颈位于子宫下端,连接着子宫宫体与阴道。 正常情况下,宫颈管口大多处于闭合状态,只有在排卵期和经期,宫颈口可有轻度松软,利于精子穿透屏障、经血顺利排出干净。
其次,宫颈在女性的生殖生育中也有着十分重要的作用,尤其在妊娠期,宫颈更要严防外界病菌侵扰胎儿,保证胎儿在宫内安全生长。
正因如此,坚强的宫颈也很“脆弱”。
由于女性独特的生理结构, 颈管内膜较薄,抵抗力弱,加之内膜皱裂多,导致宫颈不仅易发感染而且一旦发生感染还很难消除, 易诱发包括炎症、感染、瘤样病变、宫颈性不孕、宫颈性难产等各种妇产科问题。

宫颈糜烂样改变
有些患者在体检中查出 宫颈糜烂样改变 时,会很焦虑,担心这是一种很严重的疾病。实际上,宫颈糜烂样改变只是临床表象,并不一定是生病。
宫颈糜烂样改变分为生理性的糜烂和病理性的糜烂。最常见的生理性的糜烂,其实反而激素水平旺盛的一种表现:
青春期、生育期妇女雌激素分泌旺盛者、口服避孕药或妊娠期的妇女,由于雌激素的作用,子宫颈管内的柱状上皮生理性外移至子宫颈阴道部,由于柱状上皮菲薄,其下间质透出而成肉眼所见的红色,呈现宫颈糜烂样改变。
当然,出现宫颈糜烂样改变之后,也不能完全放任不管。子宫颈炎、宫颈鳞状上皮内病变、宫颈癌,也会导致病理性的宫颈糜烂。
总的来说,对于子宫颈糜烂样改变者, 往往需要通过进一步检查,如子宫颈细胞学检查(TCT)和人乳头瘤病毒检测(HPV),甚至阴道镜或宫颈活组织检查 以明晰原因,排除病理性的因素,避免延误病情。
HPV感染与宫颈癌
除了看上去吓人的“宫颈糜烂”,还有一词也经常出现在妇科体检报告上,那就是——HPV感染。
作为目前唯一一个病因清楚的妇科恶性肿瘤, 99%以上的宫颈癌组织里发现高危型HPV 。而在全球15-44岁的女性中,宫颈癌的发病率居恶性肿瘤的第二位。

正因如此,不少女性一看到自己感染HPV,就会担心自己是不是会患宫颈癌 。 事实上,感染HPV与宫颈癌之间其实还有漫长的道路。
01 安静潜伏
一般情况下,人体的免疫系统可以清除大部分的HPV。 但是还是会有一些未被清除的“余孽”会在皮肤黏膜上皮中长期“潜伏”下来。 这个潜伏期时间可以很长,且身体不会有任何症状表现。
02 择期发展
当人体的免疫功能下降时, 潜伏的HPV就会伴随着正常的细胞开始分裂、大量增殖,病毒数量迅速发展。
03 攻城掠地
如果HPV开始复制时,人体免疫系统不能及时发现,那么HPV就开始在子宫颈上皮细胞上攻城掠地,此时宫颈将迎来“改朝换代”的发展时期。
在HPV感染引起宫颈细胞变化但尚未浸润到宫颈间质细胞的这段时间称为癌前病变,即宫颈上皮内瘤变。
04 反复感染
如果高危型HPV的持续感染,那么距离宫颈癌可以说只有一步之遥。 由于癌前病变阶段,人体并不会有特别明显的症状,加上缺乏足够的科普知识,不懂得如何预防、如何定期检查,导致不少女性错过最佳的治疗时机,严重影响预后效果。
孙主任强调,在日常中女性应做好宫颈癌的预防工作,包括接种HPV疫苗以及适龄女性应定期接受宫颈癌筛查等。
宫颈炎
除了看上去吓人的“宫颈糜烂”和容易引发恐慌的“HPV感染”,还有一种病,往往得不到女性该有的重视。
很多有*生活性**的女性,都会被一种疾病困扰,那就是“宫颈炎”。它主要由感染引起,一般可分为 急性和慢性 。
其中,急性子宫颈炎可在*生活性**、流产、分娩或手术损伤后导致感染引起,或者是经期不注意卫生、*生活性**不洁等导致。
而慢性宫颈炎更多见,多是由于急性子宫颈炎治疗不彻底发展而来。

01 急性宫颈炎
症状: 阴道 分泌物增多,粘液脓性, 可伴外阴瘙痒或烧灼感。或表现为经间期出血或者同房后出血。如合并有尿路感染,还可出现尿频、尿急、尿痛。
02 慢性宫颈炎
症状: 粘稠的白色粘液状或脓性的黄色粘液状白带增多, 还可伴有外阴瘙痒、腰骶疼痛等。在临床上还可表现为慢性子宫颈粘膜炎、子宫颈息肉、子宫颈肥大。
孙主任强调,一旦发现病情后应抓紧时间采取针对性的治疗措施,否则病情有可能进一步发展到盆腔,导致盆腔炎及附件炎。再者,如果宫颈部位长期受到感染,很可能出现病变,导致不孕,严重者甚至可能发展为宫颈癌。
中医对宫颈疾病的辨证治疗
中医认为,宫颈相关疾病多归为 “带下病”、“交接出血”、“崩漏”等 范畴进行辨证论治。
最初多以白带异常为表现,故以“带下病”辨证论治为主。一般认为正虚是本病发生的内因,以肝、脾、肾三脏的功能失调为主。病因主要是湿邪为主,包括外湿和内湿。
针对包括宫颈炎在内的宫颈疾病的治疗中,常以抗生素为主, 但长期使用该类药物会使部分患者出现阴道刺痛或烧灼感、白带增多、下腹坠胀、腰酸等不良反应。
中医治疗宫颈疾病主要以 “治病求本” 为原则,从整体出发,将内服与外治相结合, 内治改善机体整体与局部免疫状态,外治提高局部抗病毒能力, 以期提高阴道局部免疫与人体免疫力。
中医治疗上,主要以除湿为主,一般治脾宜升、宜燥、宜运,治肾宜补、宜涩、宜固,湿热和热毒宜清、宜利,局部症状明显者宜配合外治法,方可提高疗效。

01 湿热下注
病因: 久居湿冷之地; 或 经期或产后或饮食不慎, 导致湿邪乘虚而入;湿滞体内化热,伤及任带,以致任脉不固,带脉失约;或平素 肝气郁结, 郁久化热肝气乘脾,脾虚水湿失运,肝火夹脾湿流注下焦,伤及任带二脉而发病。
表现: 带下量多,色黄, 或呈豆腐渣样,或脓性,或泡沫状, 气味臭秽,外阴瘙痒或灼热疼痛,小腹作痛,或腰骶胀痛,口苦口腻,胸闷纳呆,舌质红,苔黄腻。
方药: 止带方(《世补斋》)加减。
02 热毒蕴结
病因: 经期或产后, 房事不洁,或手术损伤, 致湿热之邪乘虚直犯阴户、胞宫酿而成毒;或因热甚化火成毒;或湿热遇久成毒:热毒损伤任带二脉,以致任脉不固,带脉失约发病。
表现: 带下量多,色黄或黄绿如脓,质稠, 或夹血色,或浑浊如米泔, 臭秽,小腹胀痛, 口苦咽干,烦热头晕,大便干结或臭秽, 小便黄赤,或有阴部灼痛、瘙痒,舌红苔黄或黄腻。
方药: 五味消毒饮(《医宗金鉴》)加减。
03 脾虚
病因: 素体脾虚;或劳倦过度,或饮食不节,或忧思气结, 损伤脾气;脾主运化,脾虚则水失运化,聚而成湿,流注下焦,伤及任带,以致任脉不固,带脉失约,而发为带下异常。
表现: 带下量多, 色白,质稀薄如涕如唾,无臭味,神疲乏力,胃口不佳大便不成型,面色萎黄,少气懒言,舌 胖淡,边有齿痕,苔薄白腻。
方药: 完带汤(《傅青主女科》) 加减。

04 肾虚
病因: 素体 肾气不足,或恣情纵欲,房劳多产,屡孕屡堕, 肾气虚损,或 年老肾虚 ,气化失常,水湿停聚,下注任带,以致任脉不固,带脉失约:或 肾虚封藏失职, 而致带下异常。
表现: 白带清冷,质稀如水,无臭味, 面色苍白无华,腰脊酸楚,大便稀薄或五更泄泻,尿频清长,或夜尿增多, 舌苔薄白或无苔。
方药: 内补丸(《女科切要》)加减。

孙娟主任提醒, 宫颈疾患可防可治,一定要科学治疗,坚持治疗 。
故既病则应定期筛查,早期治疗,以防病进, 发挥中医药的治疗优势,强化机体免疫功能,才能真正达到提高自身清除病毒的能力。
医生

孙娟
副主任医师
中医内科/妇科
简介
硕士毕业于中山(医科)大学,博士毕业于广州中医药大学。擅长中西医结合治疗妇科月经病,带下病,不孕症,妇科慢性疼痛及多囊卵巢综合征等常见多发疾病。尤其注重对患者亚健康状态、情绪情志等方面的调治调养。
擅长
月经不调、妇科炎症、慢性盆腔炎、多囊卵巢综合征、失眠、亚健康调理、子宫肌瘤、卵巢早衰、功能失调性子宫出血、内分泌失调
出诊时间
周六下午 固生堂广州东山分院
注:文章配图来自123rf.com.cn正版图片库。